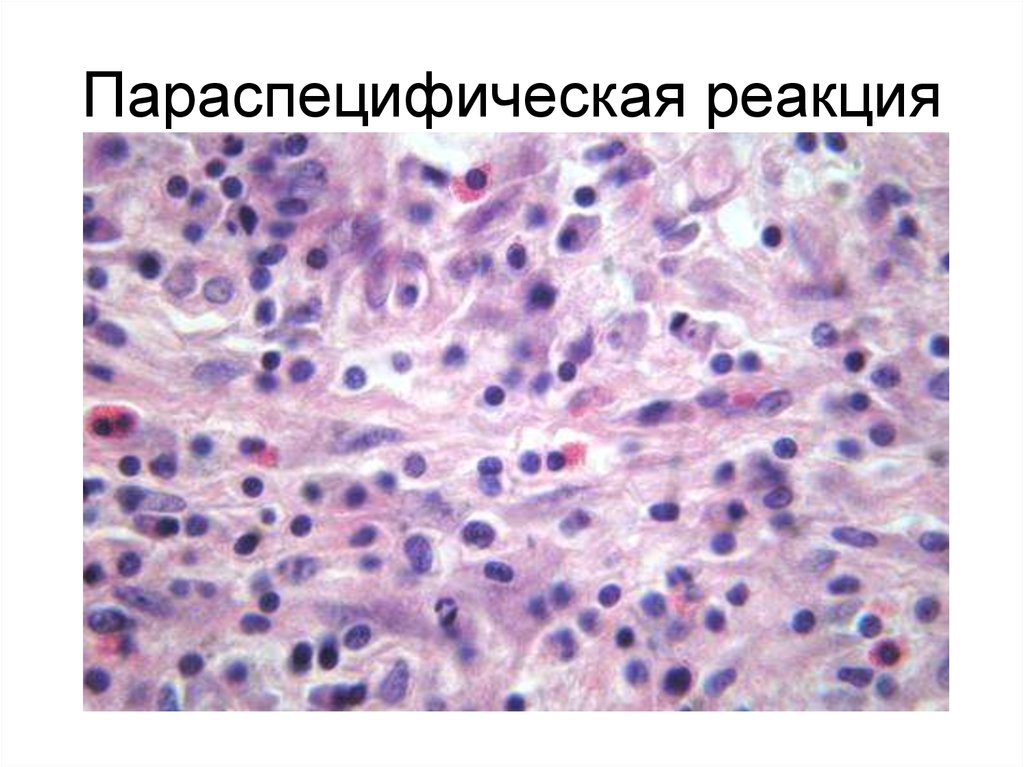
Параспецифическая реакция

Похожие презентации:
Туберкулез легких
1. Рафаэль Три грации
2.
Indocti discant et ament meminisseperiti
Незнающие пусть научатся, а
знающие пусть
припоминают (не забывают)
3.
4.
5.
6.
7.
8.
9.
10. Параспецифическая реакция
11. Параспецифическая реакция
12. Параспецифическая реакция
13. Лимфоидная инфильтрация плевры
14. Инфильтрация межальвеолярных перегородок
15. Панваскулит
16. Фибриноидный некроз межальвеолярных перегородок
17. Мелкоочаговый пневмосклероз
18.
19. Туберкулезный менингит
20.
21.
22.
23.
24.
25.
26.
27.
28.
29.
30.
31.
32.
33.
34.
35.
36.
«Очень часто смерть инфекционных больных объясняют и н т о к с и к а ц и е й,имея в виду микробов-возбудителей, продукты их жизнедеятельности, а также
продукты обмена. Отрицать воздействие этих факторов на организм и нервную
систему не приходится. Однако и сводить к интоксикации все общие явления,
наблюдаемые при инфекциях, а также причины смерти неправильно хотя бы
потому, что этот термин не раскрывает сам механизм интоксикации, не говоря
уже о том, что последняя обычно остается недоказанной. Возьмем, к примеру,
столь часто употребляемые термины «токсическая дизентерия», «токсический
грипп» и «гипертоксическая дифтерия» и т.д. Здесь происходит смешение
субъективного с объективным, ибо вместо того, чтобы тяжесть общих явлений
пытаться раскрыть физиологическими методами, мы чисто субъективно, по
принципу внешнего сходства этих общих явлений с интоксикацией принимаем их
за таковую. В огромном количестве соответствующих случаев никакой
интоксикации вообще нет, т. е. нет никакого яда, отравляющего организм, а
имеют место тяжелые расстройства нервной деятельности организма с
глубокими обменными сдвигами, ставящими организм на грань жизни.»
И.В. Давыдовский
37.
38.
39.
40. А.Дюрер Четыре ведьмы
41.
42. Пусть ВАС вдохновляют слова академика П.Л.Капицы, сказанные много лет назад, но отнюдь не устаревшие: «…наша наука – дело творческое, как и
Пусть ВАС вдохновляют слова академика П.Л.Капицы, сказанныемного лет назад, но отнюдь не устаревшие:
«…наша наука – дело творческое, как искусство, как
музыка…»

Медицина
Медицина








